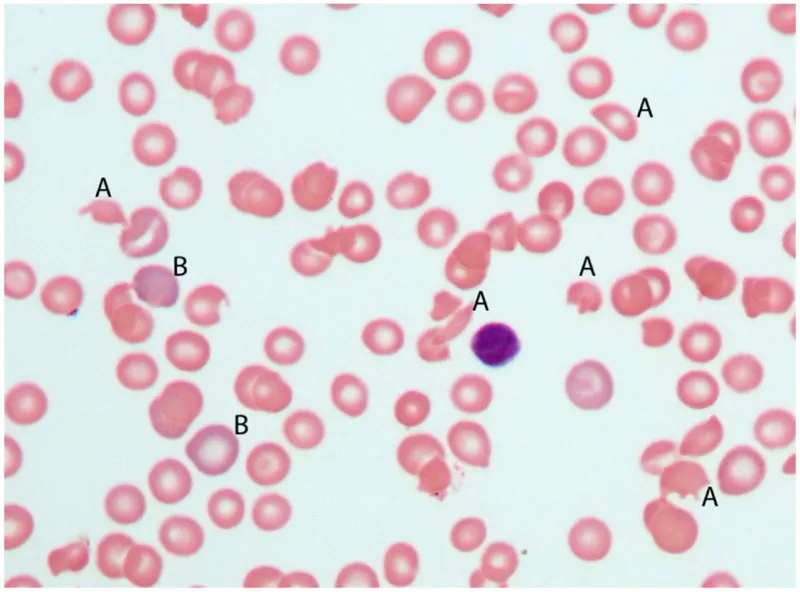
image

Normal Gestational Hemostasis - A Balancing Act

Pregnancy induces a hypercoagulable state to prevent hemorrhage at delivery. This involves a delicate shift in hemostatic balance, creating a prothrombotic environment.
- ↑ Procoagulants:
- Fibrinogen (Factor I) can increase by 50%.
- Factors VII, VIII, X, and von Willebrand Factor (vWF) also rise significantly.
- ↓ Natural Anticoagulants:
- Protein S activity decreases.
- ↓ Fibrinolysis:
- Placental PAI-1 & PAI-2 (Plasminogen Activator Inhibitors) impair clot breakdown.
⭐ The massive increase in fibrinogen is a key physiological change, preparing the body for the hemostatic challenge of childbirth.
Disseminated Intravascular Coagulation - Clotting Cascade Chaos
- Pathophysiology: Uncontrolled, systemic thrombin generation consumes clotting factors and platelets, leading to widespread microvascular thrombosis. This depletion paradoxically results in systemic bleeding.
- Primary Obstetric Triggers: Placental abruption, Amniotic Fluid Embolism (AFE), Sepsis, and HELLP syndrome.
- Clinical Signs: Bleeding/oozing from IV catheter sites, wounds, or mucosal surfaces; widespread petechiae and ecchymosis.
- Lab Findings:
- ↓ Platelets, ↓ Fibrinogen (critical if < 100 mg/dL)
- ↑ PT/PTT, ↑ D-dimer (Fibrin Degradation Product)
- Schistocytes on peripheral blood smear.
⭐ The combination of low fibrinogen and thrombocytopenia is highly specific for DIC in the setting of postpartum hemorrhage.
Specific Culprits - AFE vs. HELLP
| Feature | Amniotic Fluid Embolism (AFE) | HELLP Syndrome |
|---|---|---|
| Onset | Sudden, catastrophic, often during labor or delivery | Gradual, typically 3rd trimester or postpartum |
| Key Sx | Acute dyspnea, hypoxia, seizures, cardiac arrest | RUQ pain, nausea/vomiting, malaise, headache |
| B.P. | ↓↓ (Hypotension, shock) | ↑↑ (Hypertension) |
| Labs | Rapid consumptive coagulopathy (DIC) | Hemolysis (↑LDH), ↑AST/ALT, ↓Platelets (<100,000/μL) |
Management - The Rescue Protocol
- Treat the Underlying Cause: First, address the root of the coagulopathy (e.g., retained placenta, sepsis, amniotic fluid embolism).
- Activate Massive Transfusion Protocol (MTP): Simultaneously begin aggressive component replacement.
⭐ Cryoprecipitate is the most effective component for rapidly correcting low fibrinogen levels, which is often the critical factor in obstetric hemorrhage.
High-Yield Points - ⚡ Biggest Takeaways
- Amniotic Fluid Embolism (AFE) presents with sudden cardiopulmonary collapse and DIC.
- Abruptio placentae is a primary cause of consumptive coagulopathy, often with painful bleeding.
- HELLP syndrome (Hemolysis, Elevated Liver enzymes, Low Platelets) is a severe preeclampsia variant that can trigger DIC.
- DIC is the shared endpoint: look for ↓ fibrinogen, ↓ platelets, ↑ PT/PTT, and ↑ D-dimer.
- Treatment is addressing the underlying cause and replacing blood products (FFP, cryoprecipitate, platelets).
Unlock the full lesson and continue reading
Signup to continue reading this lesson and unlimited access questions, flashcards, AI notes, and more